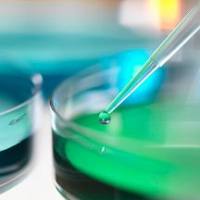
细胞冻存专用DMSO

万千商家帮你免费找货
0 人在求购买到急需产品
- 详细信息
- 技术资料
- 规格:
10T
产品介绍:
2-(4-羟基苯偶氮)苯甲酸(2-(4-Hydroxyphenylazo)benzoic acid ,英文缩写HABA)可以与亲和素特异性结合,其结合复合物为一种黄色或者橘黄色,在500nm有最大吸光值;但是其结合力远远低于生物素与亲和素的结合,当溶液中存在生物素的时候,生物素会强竞争让HABA解离下来,引起吸光值下降。基于此原理,可以根据500nm吸光值的变化计算出蛋白标记生物素的量(被标记蛋白与生物素的摩尔比)。
生物素标记摩尔比的计算是基于比尔-朗伯定律(Beer–Lambert law),又称比尔定律或比耳定律(Beer's law),是分光光度法的基本定律,即当一束平行单色光垂直通过某一均匀非散射的吸光物质时,其吸光度(Absorbance,A)与吸光物质的浓度(Consenreation,C)及吸收层厚度(length,L)成正比, 用公式表示为:A = ε*C* L其中A为光度,ε为摩尔吸光系数,所以此处公式为A 500= ε500 C L(此处ε500=34,000M-1cm-1)
主要组分:
储存条件:
该试剂盒在低温下运输,收到后请置于2-8℃保存,保存时间2年以上。
实验操作可以选择分光光度法或微孔酶标板法:
分光光度法:
A. 取900uL HABA- Avidin混合液放入1cm光程比色杯,在500nm波长测量吸光值,记录为A500(H-A);最好测量三次取平均值;
B. 在比色杯中加入100uL待测的生物素标记蛋白(Biotinylated Protein,简称BP),充分混匀后,在500nm波长测量吸光值,吸光值稳定20秒以上,记录为A500(H-A-BP);最好测量三次取平均值;如果A500(H-A-BP)<0.35,请用PBS稀释待测样品,再次重复此步骤。
微孔酶标板法:
A. 取180uL HABA- Avidin混合液放入微孔板中,在500nm波长测量吸光值,记录为A500(H-A);最好测量三次取平均值;
B. 在微孔板中加入20uL待测的生物素标记蛋白(Biotinylated Protein,简称BP),震荡或移液器吹打充分混匀后,在500nm波长测量吸光值,吸光值稳定20秒以上,记录为A500(H-A-BP);最好测量三次取平均值;如果A500(H-A-BP)< 0.3*A500(H-A),请用PBS稀释待测样品,再次重复此步骤。
案例演示:
抗体摩尔浓度计算:mM /mL=5/150000=3.33*10-5
ΔA500=(0.9*1.090)- 0.585=0.396
生物素摩尔浓度计算:mM /mL=0.396/(34000*1)=1.16*10-5
抗体:生物素(摩尔比)=(3.33*10-5)/(1.16*10-5*10)=1:3.48
2-(4-羟基苯偶氮)苯甲酸(2-(4-Hydroxyphenylazo)benzoic acid ,英文缩写HABA)可以与亲和素特异性结合,其结合复合物为一种黄色或者橘黄色,在500nm有最大吸光值;但是其结合力远远低于生物素与亲和素的结合,当溶液中存在生物素的时候,生物素会强竞争让HABA解离下来,引起吸光值下降。基于此原理,可以根据500nm吸光值的变化计算出蛋白标记生物素的量(被标记蛋白与生物素的摩尔比)。
生物素标记摩尔比的计算是基于比尔-朗伯定律(Beer–Lambert law),又称比尔定律或比耳定律(Beer's law),是分光光度法的基本定律,即当一束平行单色光垂直通过某一均匀非散射的吸光物质时,其吸光度(Absorbance,A)与吸光物质的浓度(Consenreation,C)及吸收层厚度(length,L)成正比, 用公式表示为:A = ε*C* L其中A为光度,ε为摩尔吸光系数,所以此处公式为A 500= ε500 C L(此处ε500=34,000M-1cm-1)
主要组分:
| 组分名称(Components) | 规格 | 组分说明 |
| HABA- Avidin混合液(干粉) | 1VL | 临用前加ddH2O 定容到10ml |
| PBS(pH7.2) | 30ml | 100mM 磷酸钠,150mM NaCl |
储存条件:
该试剂盒在低温下运输,收到后请置于2-8℃保存,保存时间2年以上。
实验操作可以选择分光光度法或微孔酶标板法:
分光光度法:
A. 取900uL HABA- Avidin混合液放入1cm光程比色杯,在500nm波长测量吸光值,记录为A500(H-A);最好测量三次取平均值;
B. 在比色杯中加入100uL待测的生物素标记蛋白(Biotinylated Protein,简称BP),充分混匀后,在500nm波长测量吸光值,吸光值稳定20秒以上,记录为A500(H-A-BP);最好测量三次取平均值;如果A500(H-A-BP)<0.35,请用PBS稀释待测样品,再次重复此步骤。
微孔酶标板法:
A. 取180uL HABA- Avidin混合液放入微孔板中,在500nm波长测量吸光值,记录为A500(H-A);最好测量三次取平均值;
B. 在微孔板中加入20uL待测的生物素标记蛋白(Biotinylated Protein,简称BP),震荡或移液器吹打充分混匀后,在500nm波长测量吸光值,吸光值稳定20秒以上,记录为A500(H-A-BP);最好测量三次取平均值;如果A500(H-A-BP)< 0.3*A500(H-A),请用PBS稀释待测样品,再次重复此步骤。
案例演示:
以Frdbio超级生物标记试剂盒(货号:ARL0021SK)标记Anti-Covid-19 Spike Mab (货号:nCoV-S-hMab-B),标记后测算标记比,分光光度计法。
本案例中被标记蛋白为抗体,分子量(MW)为150,000,浓度为5.0mg/mL,A500(H-A)=1.090,A500(H-A-BP)=0.585,抗体摩尔浓度计算:mM /mL=5/150000=3.33*10-5
ΔA500=(0.9*1.090)- 0.585=0.396
生物素摩尔浓度计算:mM /mL=0.396/(34000*1)=1.16*10-5
抗体:生物素(摩尔比)=(3.33*10-5)/(1.16*10-5*10)=1:3.48
风险提示:丁香通仅作为第三方平台,为商家信息发布提供平台空间。用户咨询产品时请注意保护个人信息及财产安全,合理判断,谨慎选购商品,商家和用户对交易行为负责。对于医疗器械类产品,请先查证核实企业经营资质和医疗器械产品注册证情况。
技术资料暂无技术资料 索取技术资料
Frdbio® HABA法生物素标记效率检测试剂盒
¥2580